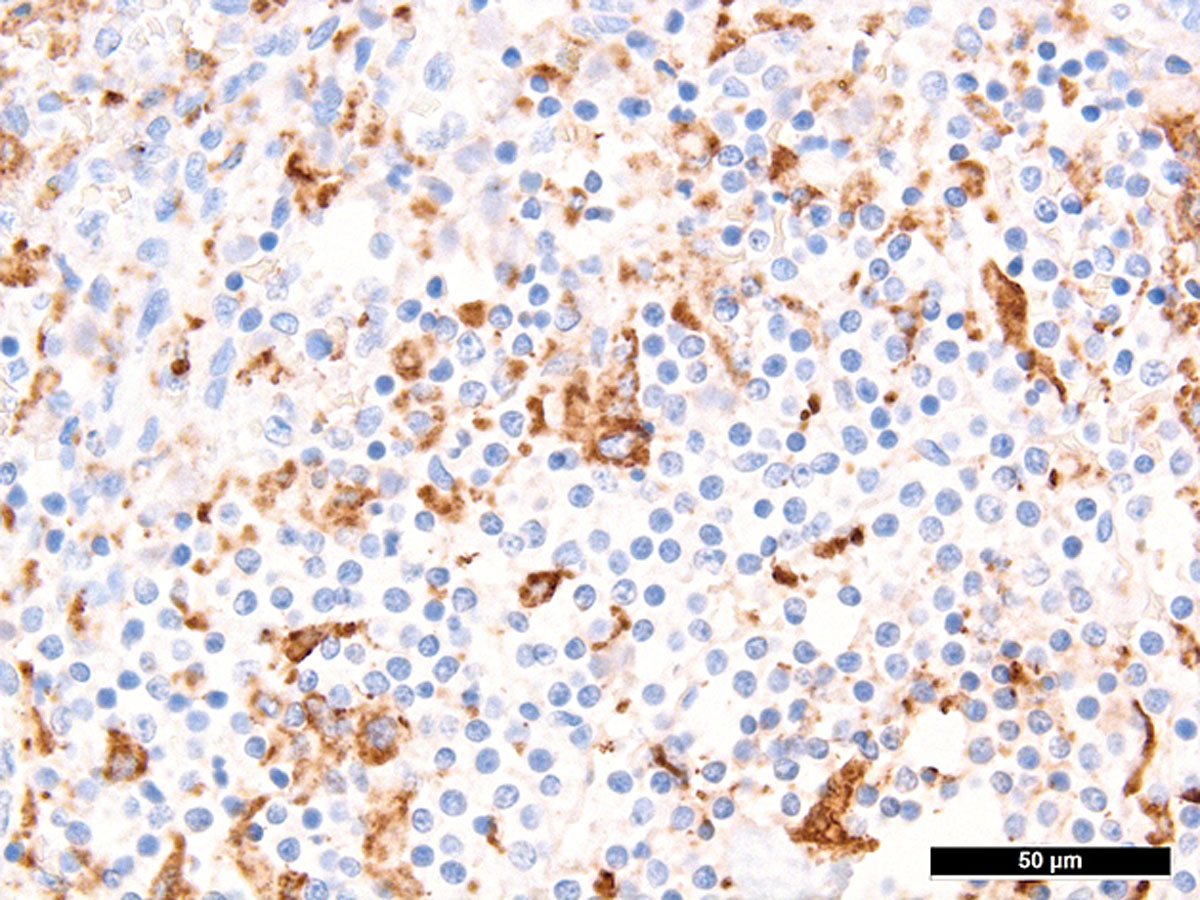

DOI: https://doi.org/10.4414/smw.2021.20420
The pandemic of severe acute respiratory syndrome coronavirus 2 (SARS-CoV-2) confronted intensive care units (ICUs) with severe and rapidly progressing cases of corona virus disease (COVID-19). As previously described by McGonagle et al., haemophagocytic lymphohistiocytosis (HLH) may occur in COVID-19 patients with acute respiratory distress syndrome (ARDS) [1]. HLH is defined as an immune-mediated disease caused by impaired natural killer and cytotoxic T-cell function [2]. This case report describes a critically ill patient who suffered from the extraordinary combination of COVID-19 and HLH with an unexpectedly dismal course despite an initial promising improvement.
A SARS-CoV-2-positive 58-year-old male presented to the emergency department with an oxygen saturation of 85%. As a results of progressive respiratory failure he was admitted to the ICU. Comorbidities included obesity (body mass index 31 kg/m2) and arterial hypertension.
The computed tomography (CT) scan at admission was consistent with an atypical pneumonia, showing ground-glass opacities with peripheral distribution affecting a quarter of the lung. Inflammatory parameters were elevated, and low-dose norepinephrine was necessary for haemodynamic support. No laboratory signs of renal or hepatic impairment were present. There were no clinical signs of thrombosis, but D-dimers were increased and, therefore, unfractionated heparin was administered prophylactically. Experimental treatments with hydroxychloroquine, lopinavir/ritonavir and tocilizumab were initiated.
After an initial increase of interleukin-6, infection markers decreased and the patient’s state improved until day 3, so that cessation of haemodynamic support was possible. On day 4, sedatives were discontinued and weaning from respiratory support initiated. During preparation for extubation, haemorrhagic airway secretions developed, accompanied by respiratory and haemodynamic instability. The CT scan showed bilateral paracentral pulmonary emboli, right ventricular dilatation and progression of infiltrates. Clinical deterioration was interpreted as acute right heart and respiratory failure due to pulmonary embolism and therefore intravenous thrombolysis was initiated. Despite immediate lysis therapy, the patient’s condition worsened rapidly. The follow-up CT on day 5 showed further increase of ground-glass opacities, and an excessive increase in inflammatory parameters with a ferritin level exceeding 17,000 µg/l (normal 30–300 µg/l) was observed. Transaminases and creatinine increased whereas C-reactive protein decreased, reflecting progressive kidney and liver failure. Figure 1 depicts values of inflammatory and liver/kidney parameters during the course of the patient’s illness.

Figure 1 Laboratory parameters over time.
On day 6, renal replacement therapy was initiated for acute anuric kidney failure, while high-dose vasoactive support was needed for haemodynamic stabilisation. Simultaneously, ferritin increased to 151,400 µg/l, which raised the suspicion of HLH. A diagnosis of HLH was supported by an H-Score of 192, indicating a probability of HLH of 80–88% [3], with the caveats that hyperferritinaemia may not be as specific in the setting of COVID-19 [4]. As dexamethasone had already been administered owing to an earlier suspicion of thrombotic thrombocytopenic purpura, no further therapy was initiated. Up to day 6, no relevant concomitant bacterial infection was present..
Multiorgan failure occurred on day 7 despite maximum medical support and steroid treatment. At that time, ferritin increased to 228,225 µg/l. With a cumulative fluid balance of +11 L, generalised oedema and capillary leak occurred. Within a few hours, progressive haemodynamic instability and multiorgan failure became uncontrollable and therefore therapy was limited. The patient died 65 hours after the diagnosis of pulmonary embolism.
Autopsy confirmed the SARS-CoV-2-infection-associated respiratory failure and pulmonary embolism leading to multiorgan failure as the cause of death. Histological findings of the bone marrow collected at autopsy showed increased haemophagocytosis (fig. 2). Haemophagocytic activity was also observable in the red pulp of the enlarged spleen (14 cm) and within the sinuses of paratracheal lymph nodes (supplementary figures S1 and S2 in the appendix). Additionally, isolated immunohistochemically positive mononuclear cells in the lymph nodes indicated a possible subtle reactivation of herpes simplex virus (HSV) infection (supplementary figure S3), which is a known complication in critically ill patients with acute respiratory distress syndrome (ARDS) [5]. A reactivation of Epstein-Barr virus (EBV), cytomegalovirus or varicella-zoster virus infection as well as infections with parvovirus B-19 and human herpes virus 8 could be ruled out post mortem by in situ examination of the lymphoid compartment, and hepatitis B and C virus infection were ruled out by means of inpatient serological examinations. Given the presence of fever, bicytopenia (anaemia and thrombopenia), hypofibrinogenaemia, hyperferritinaemia and, post mortem, splenomegaly and increased haemophagocytosis in the bone marrow, spleen and lymph nodes, six of the eight criteria of HLH-2004 were fulfilled [6]. According to the HLH-2004 guidelines, the fulfilment of five out of eight diagnostic criteria or presence of specific molecular markers are sufficient to establish the diagnosis of HLH, thus HLH could be diagnosed conclusively.

Figure 2 CD68-stained post mortem bone marrow with increased histiocytes, some with phagocytosed erythrocytes (arrowheads), consistent with haemophagocytic lymphohistiocytosis.
The distinct systemic illness of this patient with multiorgan failure made the interpretation of the laboratory findings and, thus, the diagnosis of HLH, more difficult. Even though the increasing ferritin levels initially raised the suspicion of HLH, these alone were insufficient to make the diagnosis, as Schram et al. have described [7]. In their study they identified 113 patients with serum ferritin levels higher than 50,000 µg/l and correlated them with the diagnosis of HLH [7]. Their findings suggest that a marked hyperferritinaemia is not specific for HLH, as it accompanies a great variety of conditions [7]. Ramos-Casals et al. suggest that the diagnosis of HLH has to be supported by the coexistence of different clinical, laboratory and histopathological findings, none being pathognomic alone [2]. Importantly, recent data [4] show that many COVID-19 patients present with hyperferritinaemia, and elevated ferritin levels are not accurate predictors of HLH in this setting.
In our case, the diagnosis of HLH could be established conclusively in accordance with the HLH-2004 guidelines [6]. Several viruses, especially EBV, directly linked to HLH were negative. Only possible reactivation of HSV, presumably being a consequence of the massive SARS-CoV-2-infection-induced inflammatory reaction, ARDS and mechanical ventilation [5] was observable; indeed, co-reactivation of HSV has been newly documented in critically ill COVID-19 patients [8]. HLH has already been documented in COVID-19 patients [9] and, owing to exclusion of other possible causes, SARS-CoV-2 as the initial trigger seems most likely.
In accordance with recent literature evidence [4], the HLH of our patient did not fully explain his excessively high ferritin levels. We consider the pulmonary embolus as the turning point leading to right heart failure and cardiogenic shock, followed by multiorgan failure. The documented hyperferritinaemia (151,400 µg/l on day 6) until the occurrence of pulmonary embolism is likely explained by the SARS-CoV-2-triggered HLH [6]. However, the subsequent instant and rapid increase of alanine amino-transferase and massive ferritin increase shortly after the pulmonary embolus (228,225 µg/l on day 7) is most probably the consequence of sudden congestion of the liver due to right heart failure and not due to the HLH. Supporting our hypothesis, hypoxaemic pericentral hepatocyte necrosis (20% of all visible hepatocytes) and fatty changes in 80% of the liver parenchyma were noticed on the post mortem examination, which likely led to a massive release of intracellular ferritin from the necrotic hepatocytes. Our observations suggest the need for a more tailored interpretation of hyperferritinaemia (in COVID-19) within the setting of specific clinical and laboratory findings.
This case outlines clearly the difficulty in treatment of COVID-19 and the impact of its associated complications. It indicates several learning points. First, one should consider thromboembolic events and perform respective diagnostics early. Second, full anticoagulation should be evaluated, especially in obese SARS-CoV-2 patients. Finally, the extent of hyperferritinaemia can be an expression of the acute phase reaction, HLH, liver failure or a combination of each.
We would like to thank Dr Jessica Rueff for proofreading.
The authors contributed equally to the present article
NMZ and JH collected information and wrote the case report. AT performed the autopsy and provided the histological findings and his expertise and wrote parts of the discussion. DT contributed to the interpretation of the haematological findings. MS and CEG contributed to revising and finalising the manuscript.
MS and CEG received funding by the Swiss National Science Foundation grant# 31CA30196140 and the LOOP Zurich. CEG was supported by grants from the Research Foundation in Anaesthesiology and Intensive Care Medicine, University Hospital Basel and the Research Fund of the University of Basel. AT and all consumables for in situ studies were supported by the Botnar Research Centre for Child Health.
The authors declare that they have no competing interest.
Consent for participation and publication was given by the patient’s next of kin.
1 McGonagle D , Sharif K , O’Regan A , Bridgewood C . The Role of Cytokines including Interleukin-6 in COVID-19 induced Pneumonia and Macrophage Activation Syndrome-Like Disease. Autoimmun Rev. 2020;19(6):102537. doi:.https://doi.org/10.1016/j.autrev.2020.102537
2 Ramos-Casals M , Brito-Zerón P , López-Guillermo A , Khamashta MA , Bosch X . Adult haemophagocytic syndrome. Lancet. 2014;383(9927):1503–16. doi:.https://doi.org/10.1016/S0140-6736(13)61048-X
3 Fardet L , Galicier L , Lambotte O , Marzac C , Aumont C , Chahwan D , et al. Development and validation of the HScore, a score for the diagnosis of reactive hemophagocytic syndrome. Arthritis Rheumatol. 2014;66(9):2613–20. doi:.https://doi.org/10.1002/art.38690
4 Feld J , Tremblay D , Thibaud S , Kessler A , Naymagon L . Ferritin levels in patients with COVID-19: A poor predictor of mortality and hemophagocytic lymphohistiocytosis. Int J Lab Hematol. 2020;42(6):773–9. doi:.https://doi.org/10.1111/ijlh.13309
5 Hraiech S , Bonnardel E , Guervilly C , Fabre C , Loundou A , Forel JM , et al. Herpes simplex virus and Cytomegalovirus reactivation among severe ARDS patients under veno-venous ECMO. Ann Intensive Care. 2019;9(1):142. doi:.https://doi.org/10.1186/s13613-019-0616-6
6 Henter JI , Horne A , Aricó M , Egeler RM , Filipovich AH , Imashuku S , et al. HLH-2004: Diagnostic and therapeutic guidelines for hemophagocytic lymphohistiocytosis. Pediatr Blood Cancer. 2007;48(2):124–31. doi:.https://doi.org/10.1002/pbc.21039
7 Schram AM , Campigotto F , Mullally A , Fogerty A , Massarotti E , Neuberg D , et al. Marked hyperferritinemia does not predict for HLH in the adult population. Blood. 2015;125(10):1548–52. doi:.https://doi.org/10.1182/blood-2014-10-602607
8 Le Balc’h P , Pinceaux K , Pronier C , Seguin P , Tadié JM , Reizine F . Herpes simplex virus and cytomegalovirus reactivations among severe COVID-19 patients. Crit Care. 2020;24(1):530. doi:.https://doi.org/10.1186/s13054-020-03252-3
9 Prilutskiy A , Kritselis M , Shevtsov A , Yambayev I , Vadlamudi C , Zhao Q , et al. SARS-CoV-2 Infection-Associated Hemophagocytic Lymphohistiocytosis. Am J Clin Pathol. 2020;154(4):466–74. doi:.https://doi.org/10.1093/ajcp/aqaa124
Figure S1 Haemophagocytosis in spleen.

Figure S2 Haemophagocytosis in sinus of a paratracheal lymph node.

Figure S3 Increased herpes simplex virus-infected mononuclear cells in a paratracheal lymph node.